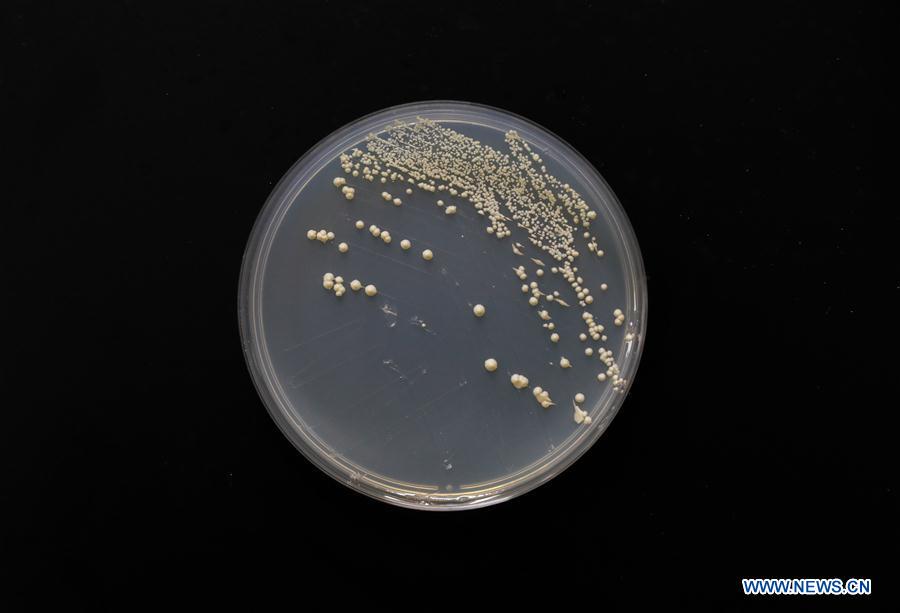

Photo taken on July 31, 2018 shows single chromosome yeast strain at the Center for Excellence in Molecular Plant Sciences, Shanghai Institute of Plant Physiology and Ecology, of Chinese Academy of Sciences in Shanghai, east China. Brewer's yeast, one-third of whose genome is said to share ancestry with a human's, has 16 chromosomes. However, Chinese scientists have managed to fit nearly all its genetic material into just one chromosome while not affecting the majority of its functions, according to a paper released Thursday on Nature's website. Qin Zhongjun, a molecular biologist, and his team used CRISPR-Cas9 genome-editing to create a single chromosome yeast strain, the paper said. (Xinhua/Ding Ting)














